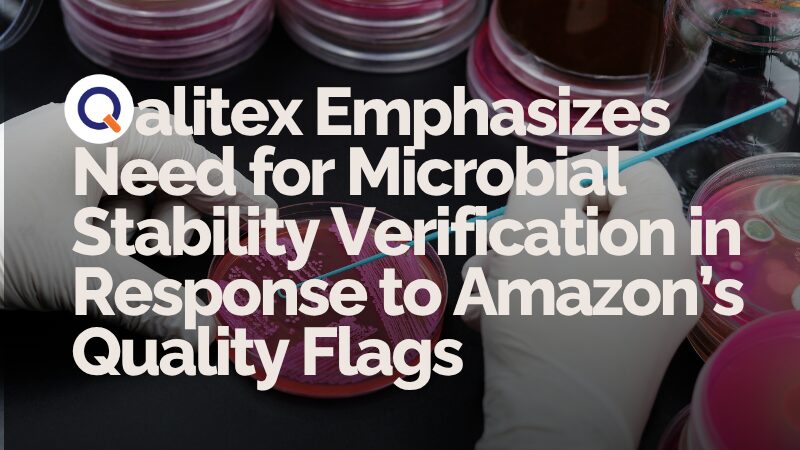

ISO 17025 Accredited Laboratory Testing for Supplements, Cosmetics, Food & Personal Care Products
Ensuring Product Safety, Quality, and Compliance Through Expert Microbiology and Chemistry Testing
Comprehensive Testing Services Tailored for Dietary Supplements, Cosmetics, Food, and Personal Care Industries
At Qalitex Laboratories, we provide ISO 17025 accredited microbiology and chemistry testing services designed to meet the rigorous standards of the dietary supplement, cosmetic, food, and personal care industries. Our state-of-the-art flaboratory, utilizes advanced instrumentation and validated methodologies to deliver accurate, reliable, and timely results. Whether you’re a startup aiming for market entry or an established brand ensuring ongoing compliance, our expert team is committed to supporting your product’s safety, quality, and regulatory requirements.
Industries We Serve
Qalitex Laboratories offers full-service and comprehensive testing in the following industries.
Analytical Chemistry to Verify Purity, Potency, and Identity
Analytical testing is essential to validate that your product contains exactly what it claims—and nothing it shouldn’t. Our ISO-compliant chemical analysis services verify active ingredient levels, detect contaminants, and confirm identity in complex matrices like powders, serums, teas, oils, and capsules.
Qalitex Laboratories works with dietary supplement brands to quantify ingredients . For cosmetics and personal care products, we test for ingredient consistency, contaminants, and unwanted residues. If you’re looking for dependable lab results backed by industry expertise, Qalitex Laboratories delivers clarity you can trust.

Microbiological Testing for Product Safety and Compliance
Microbial contamination is a leading cause of product recalls and safety concerns especially in natural, organic, and preservative-free formulations. Our laboratory specializes in microbial analysis for cosmetics, supplements, teas, and personal care items. We routinely test for pathogens like E. coli, Salmonella, yeast, mold, and Staphylococcus aureus using validated test methods and rapid turnaround.
We support formulators, brand founders, and quality control teams looking for precise, reliable, and easy-to-understand microbiological testing results. Whether you’re verifying raw materials or final product batches, Qalitex Laboratories makes microbial quality assurance simple and science-backed.
Learn More About Our Microbiological Services

Stability Testing to Support Product Shelf Life and Quality
Your product’s shelf-life or stability can make or break customer trust. We simulate real-world storage conditions—such as heat, light, and humidity—to evaluate how your product changes over time. Qalitex Laboratories stability testing services are ideal for brands developing products .
Our reports highlight changes in texture, color, phase separation, potency, microbial growth, and packaging compatibility. This is critical data for supporting expiration dates, regulatory submissions, and product claims.

Method Development and Validation for Unique Formulations
Off-the-shelf laboratory test methods don’t always fit innovative formulations. Whether you’re developing a novel botanical blend or a waterless personal care item, we build testing methods that ensure accuracy, repeatability, and regulatory alignment.
Our scientists collaborate with your R&D or QA teams to create clear documentation that supports internal protocols and external audits. It’s science, streamlined.

Why Choose Qalitex Laboratories?
Qalitex Laboratories is built for brands that value transparency, traceability, and testing support that grows with them.
Fast turnaround times with responsive client support
ISO-compliant methods and validated protocols
Easy-to-read reports for technical and non-technical stakeholders
Affordable packages for startups and growing brands
Based in Irvine, Califonria and serving clients worldwide
News

Qalitex Expands Stability Testing Services to Support Emerging Clean Beauty and Nutricosmetic Brands
Qalitex expands stability testing to help clean beauty and nutricosmetic brands validate shelf life, ensure safety, and meet retail compliance.

Qalitex Laboratories Shares Guidance on Navigating Amazon’s Evolving Compliance Requirements
Qalitex outlines key steps for Amazon sellers to stay compliant with evolving policies, focusing on documentation, labeling, and regulatory alignment.

Qalitex Laboratories on What Supplement and Cosmetic Brands Risk Without Scientific Shelf-Life Validation
Qalitex warns supplement and cosmetic brands of the hidden risks—from failed launches to reputational damage—when products go to market unvalidated.

Qalitex Highlights Role of Stability Testing in Recent Regulatory Submissions Reviewed Under Accelerated Timelines
Qalitex highlights shelf-life validation as key in regulatory submissions as agencies accelerate reviews of health-focused product categories.

Qalitex Outlines Amazon’s Standard Product Testing Requirements for Dietary Supplements and Cosmetics
Based on Amazon’s compliance expectations, Qalitex provides an overview of testing documentation typically required for ingestible and topical products.

Qalitex Issues Industry Advisory on Growing Need for Proactive Stability Testing in Supplement Formulations
Qalitex Labs releases industry advisory urging supplement brands to adopt proactive stability testing as global regulations and marketplace standards tighten.

Qalitex Laboratories Calls for Greater Industry Transparency in Stability Data Disclosure
Qalitex Laboratories Calls for Greater Industry Transparency in Stability Data Disclosure

Qalitex Advises Brands on Amazon's Heightened Scrutiny of Unsubstantiated Structure/Function Claims
Qalitex advises supplement brands as Amazon steps up claim reviews, focusing on unsubstantiated structure/function claims that trigger compliance actions.

Qalitex Labs Calls Attention to Growing FDA-Amazon Coordination on Product Compliance Investigations
Qalitex advises brands as FDA enforcement increasingly overlaps with Amazon compliance, raising the stakes for supplement sellers to maintain audit-ready files.

Qalitex Examines Impact of Supply Chain Variability on Stability Outcomes
Qalitex warns that global supply chain variability may compromise product stability; urges brands to reassess shelf-life data when sourcing or logistics change.

Qalitex Highlights Importance of Real-Time Stability Testing in Post-Market Surveillance
Qalitex urges brands to use real-time stability data in post-market checks, warning accelerated studies alone may not reflect true shelf-life.

Qalitex Urges Brands to Address Moisture Sensitivity Risks in Powdered Supplement Stability
Qalitex advises brands to address moisture risks in powdered supplements, warning that humidity exposure can undermine shelf-life and microbial stability.

Qalitex Advises on Photostability Gaps in Cosmetics with Botanical Actives
Qalitex warns that light exposure can degrade botanical cosmetics and urges brands to close photostability testing gaps often missed in shelf-life validation.

Beauty Safety Expert Nour Abochama Weighs In on the Lack of Standardized Definitions in 'Clean Beauty' Marketing
Chemical engineer and regulatory operations expert Nour Abochama explains why terms like “clean,” “non-toxic,” and “natural” remain unregulated and potentially misleading.

Qalitex Warns of Compliance Risks from Undocumented Temperature Excursions During Distribution
Qalitex urges brands to document temperature excursions in transit, warning of rising regulatory demands for real-world stability validation.

Qalitex Raises Concern Over Stability Data Gaps in Novel Dosage Formats
Qalitex urges brands to reassess how gummies, stick packs, and other novel formats are validated, citing unique stability challenges overlooked by standard protocols.

Qalitex Cautions Against Overreliance on Accelerated Stability Data for Product Launches
Qalitex warns brands not to rely solely on accelerated stability data, emphasizing the need for real-time studies to validate shelf-life and product performance.

Qalitex Examines Risks of Cross-Contamination Affecting Microbial Stability in Shared Facilities
Qalitex highlights how shared manufacturing facilities may increase microbial instability risks that impact shelf-life claims and delay product launches.
Qalitex Emphasizes Need for Microbial Stability Verification in Response to Amazon’s Quality Flags
Qalitex highlights importance of microbial stability testing to address Amazon’s product quality flags related to contamination risks and shelf-life control.

Qalitex Discusses Stability Testing Needs for Products Marketed Under Multiple Climate Zones
Qalitex highlights the need for stability testing across multiple climate zones to ensure shelf-life accuracy in international markets beyond standard ICH conditions.